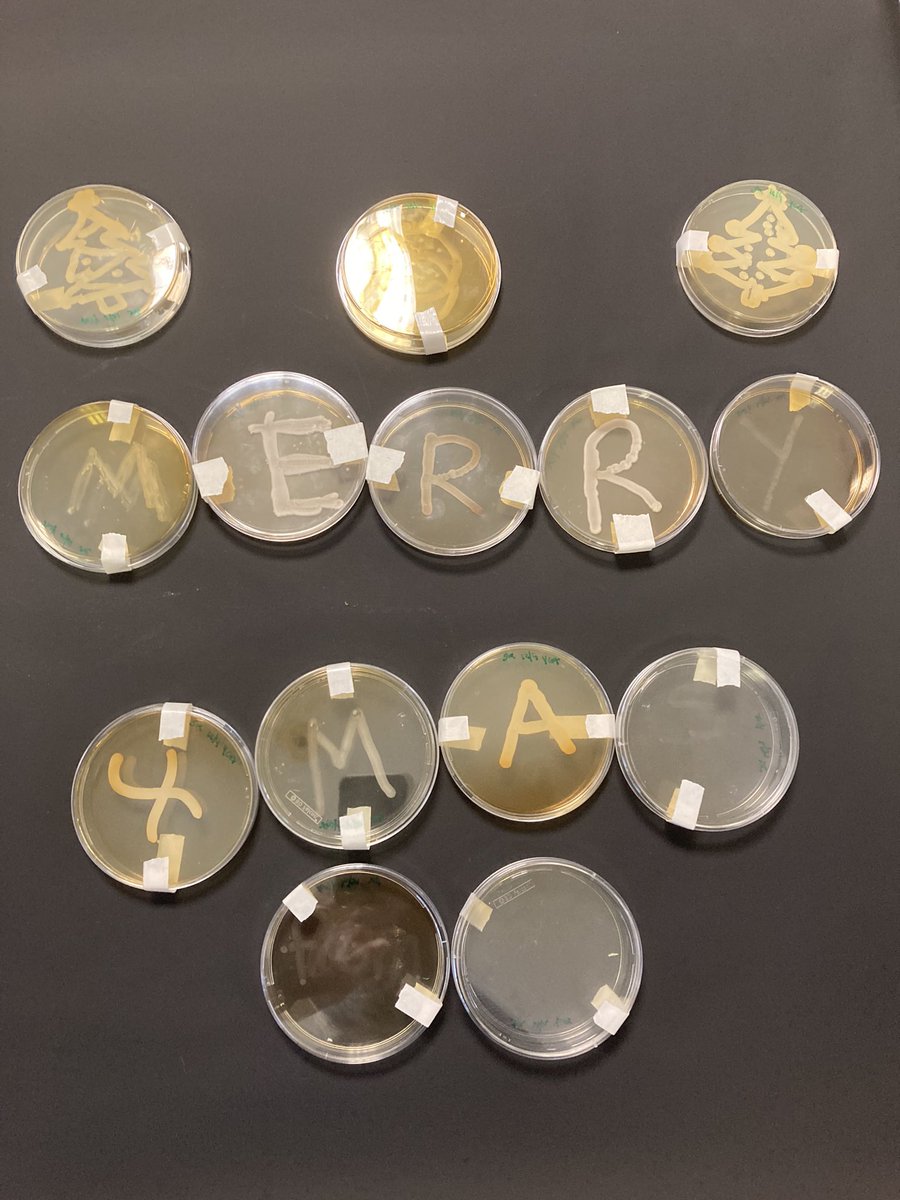
Merry Christmas from the biology department <a href="/knoxacademy/">Knox Academy</a> (and some willing yeast!) #microbiology #yeast

Knox Biology
@knoxbiology
AMBITION | RESPECT | COMMUNITY - The Biology Department at Knox Academy - Follow the main school account @knoxacademy
ID: 1101146466851176448
http://ka-net.org.uk 28-02-2019 15:45:50
226 Tweet
114 Followers
106 Following

P7 transition pupils doing flame tests. Excellent work everyone. See you in August Knox Academy


S3 are coming to the end of the "Our Green World" topic and we hope they now love plants as much as we do!💚🌱🪴🌾🌿🍃 Knox Academy


Had a great time welcoming some future scientists into the department during the P7 parents night, was lovely to meet you all🤩👩🔬👨🔬 Knox Academy Knox Academy - Science Faculty


Our S3's catching up on a classic practical they missed in S1 due to covid! You can't beat looking at your own cheek cells!! 👀😯 Knox Academy



Had a reflective day at #BHSPedagogy today with five other colleagues from Knox Academy. Lots of information on how to improve learning & teaching from Bruce Robertson, Derek Huffman & ideas for behaviour management from Dr Bill Rogers #CLPL #selfimprovingschools


Great to be with Knox Academy - Head Teacher, @BorwickL_PE, Miss Bates, @BlairCalum4 and Mr Flood at the #BHSPedagogy event! Knox teachers being life long learners 💫


The Biology department are busy tonight making treats for tomorrow's bake sale! These cheese scones smell delicious! 😋 Knox Academy


Merry Christmas from the biology department Knox Academy (and some willing yeast!) #microbiology #yeast

Raising awareness of Diabetes UK and learning about glucose regulation at the same time! Our S3's using their list of patient symptoms, "urine" clinistix results and Benedicts to give a diagnosis. 👏👏 #keeplearningrelevant Knox Academy


Chromatography of photosynthetic pigments in higher biology today. Even managed to get some xanthophyll showing up 😊 Knox Academy #chromatography #chlorophyll


Nat 5's discovering where Carbon Dioxide gets into a leave and where Oxygen comes out!!!These pores are known as stomata! The surrounding structures which open in the day and close at night are guard cells 💚🌱🌿! Plants are soooo cool!!!! Knox Academy Royal Society of Biology


Our biologists carrying out an experiment to practice Mendelian genetics. With thanks to Josh from Edinburgh Napier University for visiting us! Knox Academy Knox Academy - Science Faculty


Great start to activity week yesterday with S1 pupils on a nature walk around Haddington Knox Academy


Another great day of exploring nature on our doorstep during Knox Academy activity week. Great work on checklist challenges and collages today






